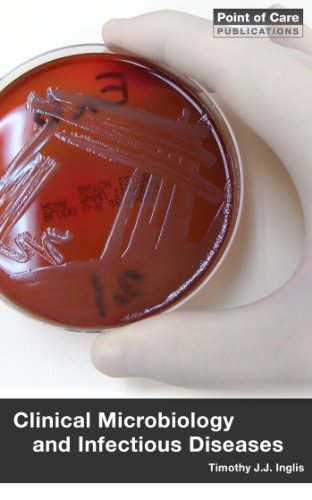

Clinical Microbiology and Infectious Diseases
Product Description
Condition - Very Good
The item shows wear from consistent use but remains in good condition. It may arrive with damaged packaging or be repackaged.
Clinical Microbiology and Infectious Diseases
Self-directed learning and revision guide to clinical microbiology and infectious diseases for student doctors, nurses and allied health professionals. This eBook contains self-assessment questions in a range of exam formats (MCQ, ECQ, data interpretation and discussion/oral), worked answers and detailed text in an accessible format. The contents follow three main themes: introductory concepts, diseases and syndromes in clinical practice, and thematic glossaries (bacteriology, virology, parasitology, mycology, antimicrobial chemotherapy agents and laboratory tests).





